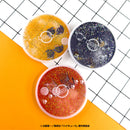
【ハイキュー！！】グリッターコースター

説明
【特長】
傾けるたびにグリッターが揺れる可愛いアイテム!
中にはキャラクターフレークが入っています
【仕様】
・サイズ:φ110mm×D8mm
・素材:本体(ポリカーボネート)/カバー(シリコン)
※商品発送には10~15日程度のお時間を頂く商品になっております
予めご了承ください。
・モニターの仕様などにより写真と商品の色が多少異なる場合があります。予めご了承ください。
・小さな子供の手の届かないところに保管してください。
・お客様都合による返品交換はお受けできかねます。予めご了承くださいませ。
例:イメージと違う、機種・デザインを間違えて購入した など
※当店で販売しているすべてのグリッター商品の中の液体は
【ホワイトオイル】と呼ばれる皮膚などに付着した場合でも
火傷など生じることのない、化粧水などにも使用されている
人体に害のない安全性の高いオイルでございます。
スマホケースなどで国民消費者センターより注意勧告のある内容物・使用液体とは
まったく異なりますので安心してご使用くださいませ。
🄫古舘春一/集英社・「ハイキュー!!」製作委員会
Payment & Security
お支払い情報は安全に処理されます。 クレジットカードの詳細を保存したり、クレジットカード情報にアクセスすることはありません